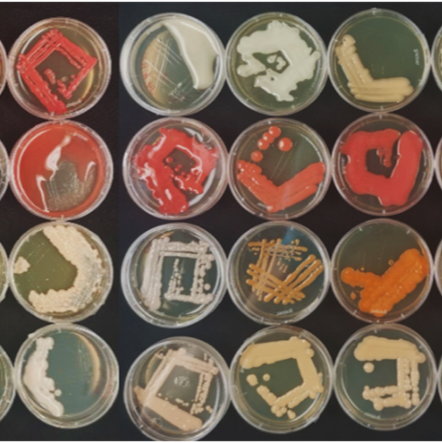
Microbe isolation and taxonomic classification from environmental samples

Nov 14, 2022
Microbe isolation and taxonomic classification from environmental samples
- Yiheng Hu1,
- Alexander Kirbis2,
- Eric Kemen1
- 1Center for Molecular Biology of Plants (ZMBP), University of Tuebingen;
- 2Center for Data Processing (ZDV), University of Tuebingen

Protocol Citation: Yiheng Hu, Alexander Kirbis, Eric Kemen 2022. Microbe isolation and taxonomic classification from environmental samples . protocols.io https://dx.doi.org/10.17504/protocols.io.14egnx5eyl5d/v1
License: This is an open access protocol distributed under the terms of the Creative Commons Attribution License, which permits unrestricted use, distribution, and reproduction in any medium, provided the original author and source are credited
Protocol status: In development
We are still developing and optimizing this protocol
Created: August 11, 2019
Last Modified: November 14, 2022
Protocol Integer ID: 26799
Keywords: Microbe isolation, Microbiome, taxonomic classification, protocol for microbe isolation, microbe isolation, microbe strain, number of microbe strain, microorganism, associated microorganism, taxonomic classification from environmental sample, isolation, taxonomic classification, different host sample, strain, insect, environmental sample
Abstract
Numerous studies on plant,animal, or insect-associated microorganisms have significantly impacted host, and the number of microbe strains collected from different sources is exploding. However, the protocol for microbe isolation from different host samples is still not standardized. Here we designed a protocol for isolating, and more importantly, organizing culturable, aiming to make this process more reproducible and less time-consuming.
Guidelines
This protocol generally started from a culture plate containing colonies from mixed species, and end with a collection and a list of organized unique microbe species based on marker gene sequences.
Materials
This protocol will take days to weeks to complete and including several experiments. The material and instrument for each experiment at each section are all mentioned in detail in each step.
Before start
Process the raw sample according to different organisms and plate the microbe solution on agar plates of choice. We mainly work on plant leaf-associated microbe collections, so we normally grind the leaf in water and filter out the leave content with sterile filters. Then we plate the filtrate containing all microbes on different media plate including Potato Dextrose Agar, Malt Extract Agar for fungal isolations, LB-agar, NB-agar and R2A for bacteria isolations.
Sub-culturing
First round subculturing
From the plate of initial streaking, try to pick single yeast or bacterial colonies from each dilution onto plates with grids. Make sure the plate is labeled with a date and other necessary information for your particular experiment (e.g. growing temperature, media, etc.), then take a photo of each plate.
For filamentous fungi, use the tip to cut a small square from the growing edge of each growing colony and place it on the middle of a small plate (5.8cm diameter).
Put those first-round subcultures on to 22oC for >2 days
Second round subculturing:
From day 3, bacteria and yeast colonies will start to become visible from the standard plates with grids, which look like this:
An example PDA plate with different yeast isolates.
From this large plate (12cm diameter), isolate them and re-streak them onto small plates (5.8cm diameter). Add antibiotics if necessary (e.g. fungal isolation). Then put them into 22oC for sub-culturing
From day 3 of the second round subculturing, check every day for the isolate that already grows well, and put those into the cold room.
(Optional) To be extremely organized, we could use a 48L plastic box for storage of the small plates. The long edge of the box (~60cm) can fit exactly 8 stacks of small boxes with 12 plates on each stack. In this case, each row of the box will be exactly 96 plates for one 96 well colony PCR.
Colony PCR
Prepare buffer in each 96 well plate:
For bacteria use 40uL TE buffer, for fungi use 30uL 10% Chelex + 10uL TE buffer.
From each individual small plate, use 10uL pipette tip to pick a small amount of microbe tissue and place into each well of the 96 well plate with buffer. For fillamentous fungi, try to avoid agar and only take the mycelium.
After finish one row (12 well), take the tip out and try to press the remaining buffer within the tip back into the well, by pressing the back of the tip with a finger.
After all wells are filled with microbe tissue, cover the plate, vortex briefly and spin down.
Put the plate into Thermocycler and set it as follows:
15 mins @ 60oC
10 mins @ 99oC
2 mins @ 4oC
5 mins @ 99oC
Maintaining @ 10oC.
During the Thermocycler is running, prepare the PCR reaction MasterMix as follows (We used FirePool mastermix):
5X PCR mastermix 4 uL
ITS1F/27F 0.5 uL
LR6/1492R 0.5 uL
Water 13 uL
Make 100X mastermix and distribute 18 uL into another 96-well PCR plate (Volume might differ if using different PCR mastermix).
After the boil-freeze-boil cycle is finished, take the DNA plate out and centrifuge for 1min at 2000g.
Now we could see cell debris and Chelex at the bottom of the tube.
Take 2uL of the supernatant from DNA plate and pipette them into the corresponding well in the PCR plate using a multichannel pipette.
After finishing the whole plate, seal both plates, and vortex the PCR plate followed by a quick spin.
After spinning down the reaction, place the PCR plate on a Thermocycler and set it as the manufacturer's protocol of the PCR mastermix. Here we use ours (FIREPol 5X PCR mastermix) as an example:
5 mins @ 95oC
{
30s @ 95oC
40s @ 56oC
90s @ 72oC
} X 30 cycles
5 mins @ 72oC
Maintaining @ 10oC
After the PCR reaction is finished, run them on a 1% Agarose gel. An example result is shown here:
An example colony PCR result.
Before processing the experiment further, we need to first generate some documents for recording.
This is very important as this whole experiment can be time-consuming and can easily become messy.
For recording, each microbe isolate needs to have a unique ID. This unique ID should be automatically generated after filling the first SWATE template of sampling metadata. Here is our example:
YH.WH.Y1: Yiheng Hu (YH) isolated from Location WH, Yeast isolate 1 (Y1).
Yeast isolates can be replaced by: ‘B’= Bacteria; ‘F’= Filamentous fungi, 'O' = Oomycete
The ID of each microbe isolate will appear on each small plate, and on the recording excel files. In this case, we can link the 96 well DNA plate with each small plate of microbe culture. The first recording file is as follows (Template will be in the SWAT plugin of excel):
| A | B | C | D | |
| ID | Position | Col_PCR result | Notes | |
| YH.WH.Y1 | A1 | |||
| YH.WH.Y2 | A2 | Y | ||
| YH.WH.Y3 | A3 | Y | ||
| YH.WH.Y4 | A4 | Y | ||
| YH.WH.Y5 | A5 |
The layout of colony PCR record excel file. In the Col_PCR result column, Y means the yeast colony is PCR positive with fungal primer. B means the colony is positive with bacterial primer, F means filamentous fungi is positive with fungal primers. Empty means PCR negative. Sometimes I put some notes about the observations from the culture plate in the 'Notes' column.
High fidelity PCR and Sanger sequencing
After a few rounds of colony PCR, we have many samples with positive PCR results. Now we need to pipette the DNA from these positive samples and merge them into a new 96 well plate. This step will generate a new recording table named as 'Merged DNA plate from positive colony PCR.xlsx', and each table corresponds to a plate in the freezer:
| A | B | C | D | |
| ID | Position from the original plate | Col_PCR result | Position in merged plate | |
| YH.WH.Y2 | A2 | Y | A1 | |
| YH.WH.Y14 | B1 | Y | A2 | |
| YH.WH.Y16 | B2 | Y | A3 | |
| YH.WH.Y18 | B4 | Y | A4 | |
| YH.WH.Y19 | B5 | Y | A5 |
The layout of the merged DNA plate from the positive colony PCR excel file. The position in the merged plate corresponds to the plate stored in -20
For us, we only used 95 wells out of 96 since one well in the Sanger sequencing plate needs to be kept empty as an internal control.
With the new merged DNA plate, we can run a high fidelity PCR with proofreading polymerase e.g. Q5, Fusion.
We used 50uL of Q5 reaction:
5X Q5 buffer 10 uL
High GC enhancer 10 uL
dNTPs 1 uL
ITS1F/27F 2.5 uL
LR6/1492R 2.5 uL
Q5 0.5 uL
DNA 2 uL
Water 21.5 uL
Make 96X mastermix and distribute 48 uL into another 96-well PCR plate.
Take 2uL DNA from the merged DNA plate and pipette them into the corresponding well in the PCR plate using a multichannel pipette.
After finishing the whole plate, seal both plates, and vortex the PCR plate followed by a quick spin.
After spinning down the reaction, place the PCR plate on a Thermocycler and set it as the manufacturer's protocol of the polymerase. Here is our setting of Q5:
30s @ 98oC
{
10s @ 98oC
20s @ 56oC
40s @ 72oC
} X 33 cycles
2 mins @ 72oC
Maintaining @ 10oC
Next, we clean up the PCR products with magnetic beads (The protocol for homemade bead is separate).
First we add 0.8 volume (40uL) of self-made magnetic beads to each well of a 96-well round bottom plate.
Transfer all the PCR product to the prepared round bottom plate and mix for 3 mins at 1000rpm on a thermoblock at RT (or pipette up/down for 10 times), then let it rest covered for 5 mins.
Place the 96-well round bottom plate on the magnetic plate and let the beads reach the edge of the well (~3 min), remove the supernatent. During the waiting, prepare >50mL 70% ethanol.
Keep the 96-well round bottom plate on the magnetic rack, and wash each well twice with 180uL 70% ethanol using a multichannel pipette and a solution reservoir. Note: The beads should not re-suspend!
After removal of the second wash, let it dry for at least 2 min.
Note: Check for small cracks in the beads spot. Wait until some crack appears before proceeding further.
Add 20uL of 10mM Tris HCl pH8 into each well, remove from the magnet and place the plate on the thermoblock at RT and shake for >20 mins at 1000 rpm.
Place the 96-well round bottom plate on the magnet rack again for 5 mins, then pipette the DNA suspension into a new 96-well plate
During the waiting, take out a sequencing plate and pipette the forward primer into each well.
The amount of primer depends on the requirement of each Sanger sequencing facility.
Measure DNA concentration with NanoDrop for some wells, calculate the average concentration and pipette the required amount of DNA into each corresponding well of the sequencing plate. We used Eurofins Genomics who requires 150ng of DNA in 15uL plus 2uL 10uM primer.
Send the plate for sequencing and keep the DNA plate in thefreezer.
We normally send the sequencing plate with forward primer first, and perform a brief troubleshooting for some of the wells before sending the sequencing plate with the reverse primer.
For trouble shooting when sanger sequencing failed for certain wells, we check Nanodrop for tjose those failed wells again:
1. If the concentration is too high (>2 fold of the average concentration of input), adjust it when submitting the reverse sequencing;
2. If the concentration is too low or the quality is too bad, use a different polymerase or the original PCR mastermix to re-run PCR again, purify the PCR product and replace the well with the new DNA.
3. If the concentration is fine, then just send the reverse sequencing directly, as the failing of this sample could be due to the sequencing run itself.
After troubleshooting, send another sequencing plate for the same samples with the reverse primer for Sanger sequencing.
The Sanger sequencing needs to be recorded properly and the data needs to be stored.
For each sequencing plate, we need to record the sample ID and the primer at each position:
| A | B | C | |
| Position | Sample | Primer | |
| A1 | YH.WH.Y2 | ITS1F | |
| A2 | YH.WH.Y14 | ITS1F | |
| A3 | YH.WH.Y16 | ITS1F | |
| A4 | YH.WH.Y18 | ITS1F | |
| A5 | YH.WH.Y19 | ITS1F | |
| A6 | YH.WH.Y20 | ITS1F |
The layout of the excel table for recording Sanger sequencing plate. The file name are YYYYMMDD_plateID.xlsx
The data of each plate will be stored at a folder named Sanger sequencing
DNA extraction and Sanger sequencing
For the samples with negative colony PCR results, we extract the DNA from their tissue and re-do the PCR and Sanger sequencing again. This step will generate a new recording table named as 'DNA extraction samples from negative colony PCR.xlsx':
| A | B | C | D | |
| Extracted? | PCR posiitive? | Position in merged plate of PCR products | ||
| YH.WH.Y1 | Y | Y | A1 | |
| YH.WH.Y3 | Y | Y | A2 | |
| YH.WH.Y4 | Y | Y | A3 | |
| YH.WH.Y5 | Y | N | ||
| YH.WH.Y7 | Y | Y | A4 |
The layout of the recording for the DNA extraction samples. The 'Y' here means YES and 'N' means NO.
In this process, we store all the DNA in 1.5mL Eppendorf tubes and put them in separate boxes in a -20oC freezer.
We perform DNA extraction with commercial kits following the manufacturer's protocol. Although this step is quite straightforward, we have the following two recommendations:
1. Use column-based kits instead of precipitation-based kits if possible. Precipitation methods often are used for preserving high molecular weight DNA, but for our purpose this is not necessary. Column-based kits are much faster and the DNA quality&quantity is often guaranteed.
2. Prepare all the microbe tissues together and kept in -80oC freezer for bulk extraction later. This way is more organized and time-saving, as we do not need to crush samples in liquid nitrogen every time.
Generally, take 20 - 50mg tissue directly from the plate and place it in a 2mL Eppendorf tube. Freeze the tubes in liquid nitrogen and add two metal balls (3mm in diameter) inside. Put all the frozen tubes in a Qiagen Tissuelyzer II and shake for 3 rounds of 30s @ 25Hz. Put tubes back to liquid nitrogen between every two rounds.
After the DNA extraction, we measure DNA concentration with Nanodrop, and perform a PCR test with PCR Mastermix to check if their marker gene can be amplified. Record the Y/N results in the excel table based on the gel image.
If it is still not possible to amplify the marker gene region of certain microbes until this step, we normally ignore them.
Follow the same procedure from step #13 to step #22, run Q5 PCR using DNA from positive samples of the previous step and clean up the PCR products.
Measure the concentration of all PCR products, and send them for Sanger sequencing using either plate or individual tubes, depending on the number of PCR products. (We use plates for every 95 samples)
Data collection and Taxonomic assignment
After all Sanger sequencing runs are finished, the abi files (sequences with base quality) can be extracted.
It is better to store them for two copies, one in the cloud storage and the other local copy. We use the DataPLANT platform to store our raw abi data.
Secondly is to record the result of each sequencing run in the metadata table. An example is as follow:
| A | B | C | D | E | F | |
| primer1 | Parameter [primer 1 data ID] | primer1_pass? | primer2 | primer2 data ID | primer2_ pass? | |
| 27F | MON2941_G3 | N | 1492R | MON2941_H3 | N | |
| ITS1F | MON2941_A5 | Y | LR6 | MON2941_D5 | Y | |
| ITS1F | MON2941_A6 | Y | LR6 | MON2941_D6 | Y | |
| 27F | MON2941_G4 | Y | 1492R | MON2941_H4 | Y |
For each PCR product, two sequencing runs are recommended, since Sanger sequencing can also include errors and issues in the homopolymer regions.
If two sequencing runs are performed, then do an alignment with the two abi files for each PCR product. After the alignment, manually extract the high quality region and use it for taxonomic assignment and data storage (fasta format). Here is an example of how we determine the 'high quality' regions:
We only keep the selected region.
With the extracted high-quality region, run blast against the NCBI nucleotide database to determine the species. Record that in the metadata table 'workflow_taxonomic_assignment' section
(Optional) Generating unique strain table
The first step is to generate a phylogenetic tree with all sanger sequencing data.
